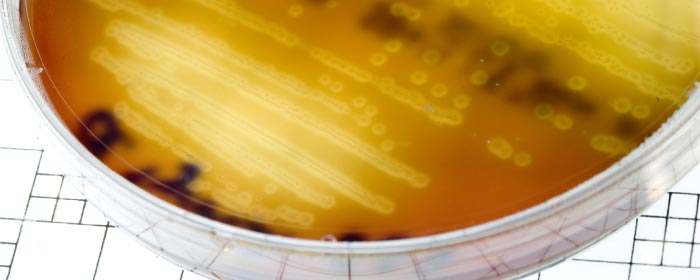

Home » Biotechnology » Industrial Microbiology
In the field of industrial microbiology, we seek to transfer all the possibilities of microorganisms in order to solve a wide variety of problems.
We study the different processes mediated by microorganisms on a pilot and industrial scale and we work on their optimisation and implementation for purposes such as the generation of high value products (fermentation), synthesis of biopolymers (generation of bioplastics), improving the properties of green chemistry products (biosurfactant, biodetergence), optimising soil biostabilisation (biocementation), wastewater treatment (biological water purification processes), and the bioremediation and biostimulation of contaminated soils and industrial waste. These last two processes are described in detail in the Environment section.
We work on the diagnosis, isolation and control of microbial contaminants in industrial processes in various sectors (food, cosmetics and personal hygiene companies), carry out antimicrobial studies (as per ISO, UNE, ASTM and JIS standards) and treat biofilms to test a wide range of products (pharmaceutical, cosmetic, medical, textile and paint compounds, among others).

The aim of this project is to modify textile fibres in order to obtain fibres with improved properties that are relevant to the textile industry, e.g. mechanical, antimicrobial or anti-odour properties.
Subsidised by the Basque Government

The main aim of XMILE is to investigate the production of bacterial exopolysaccharides with the biotechnological potential to create products of high industrial value in the biomaterials, food and health sectors. GAIKER will study the biological functionality of these compounds and select the most promising candidates for future applications in dermatology and food.
Subsidised by the Basque Government

The overall aim of the project is to develop an economically viable bacterial cellulose production process based on super-producing micro-organisms by using by-products from the food industry as a fermentation medium to obtain an innovative high-value product for the food industry.
Subsidised by the Basque Government
The main aim is to obtain new microbial detergents for formulating new cleaning products for the agri-food industry, among others. These products have the advantage of being biodegradable and able to replace other cleaning ingredients that are more aggressive towards the environment and users.

Development of a sustainable land-based cultivation process of mullet, by formulating and applying diets enriched with microalgae and incorporating improvements in water recirculation systems (WRS) with the aim of obtaining a highly nutritious end product with a high market value
Programme: aid to the fisheries and aquaculture sector in the Autonomous Community of the Basque Country, as set out in Regulation (EU) No 508/2014 of the European Parliament and of the Council of May 15, 2014 on the European Maritime and Fisheries Fun (EMFF)
Subsidised by the Basque Government

The objective is to make diagnostic, technological and therapeutic innovations in pulmonary hypertension associated with heart failure and idiopathic pulmonary fibrosis.
Subsidised by the Basque Government
